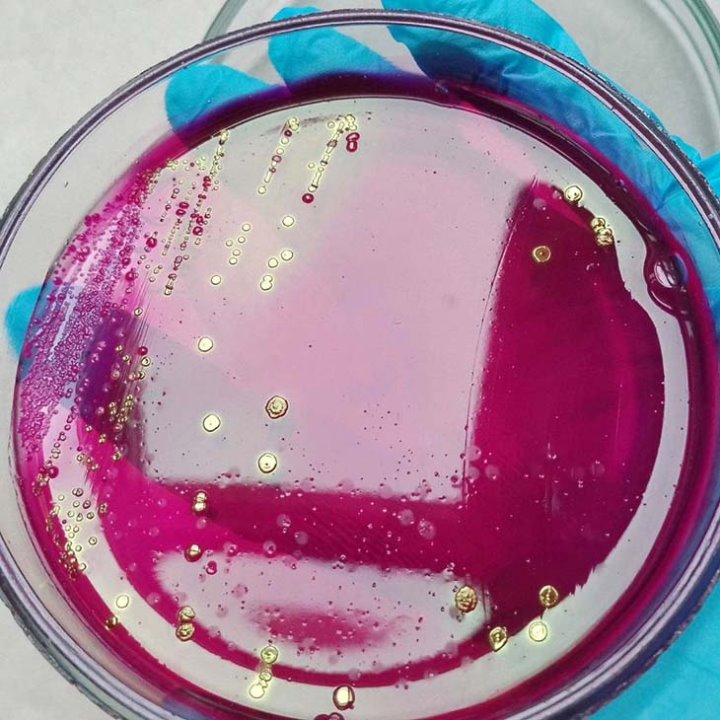
Разрешаете детям купаться в фонтане? Специалисты центра гигиены взяли воду на анализ — смотрите, кого там нашли
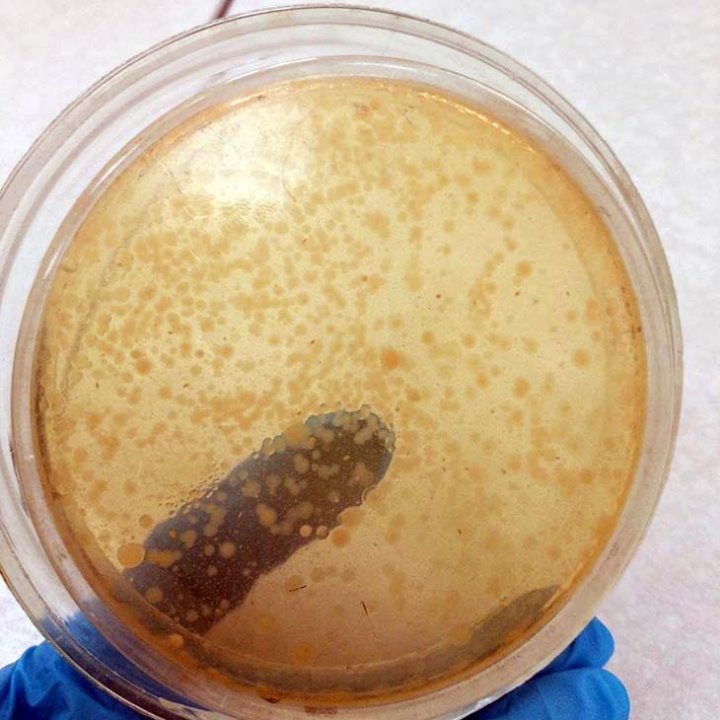
Разрешаете детям купаться в фонтане? Специалисты центра гигиены взяли воду на анализ — смотрите, кого там нашли

4 июля Могилевский зональный центр гигиены и эпидемиологии (МЗЦГЭ) проверил воду в городских фонтанах на безопасность, и уже 9 июля поделился фотографиями тех, кто обитает в этой воде. Чем купание в городских фонтанах чревато для здоровья, рассказали в МЗЦГЭ.
Фонтаны созданы для эстетического наслаждения и охлаждения в жару (находясь возле фонтана), а не для купания в них.
Вода в таких местах не подвергается водоподготовке и не предназначена ни для купания, ни для питья. В процессе эксплуатации вода в фонтане обновляется не часто, и кроме того не очищается и не обеззараживается по требованиям предъявляемым для бассейнов, предназначенных для купания и занятия спортом. Высокая температура воздуха также способствует размножению микроорганизмов. Развлечение в фонтане чревато не только простудой, но и более серьезными заболеваниями.
Купание в фонтане может обернуться острой кишечной инфекцией, респираторной инфекцией, конъюктивитами, главную же опасность представляют энтеровирусные, ротавирусные инфекции, вирусный гепатит А.
Более того, можно получить травму при падении, а также электротравму, так как к фонтанам подведены различные коммуникации и подсветки.
В рамках изучения данной темы, 4 июля специалисты МЗЦГЭ произвели отбор проб воды из фонтанов, пользующихся наибольшей популярностью у горожан и гостей города.
Отобранные из фонтанов пробы доставлены на исследование в лабораторию для проведения микробиологических и паразитологических испытаний.
Поскольку для воды в фонтанах не предусмотрены какие-либо гигиенические нормативы, специалисты оценивали фактическое полученное значение показателей микробиологической безопасности. Для того, чтобы результаты можно было оценить, они сравнили фактически полученные результаты с гигиеническим нормативом микробиологической безопасности для питьевой воды систем централизованного водоснабжения (для воды, которую мы ежедневно получаем из крана) и нормативами для поверхностных водоемов (т.е. для зон купания). И получились следующие результаты:

Таким образом, полученные результаты в очередной раз подтвердили необходимость соблюдения мер безопасности.